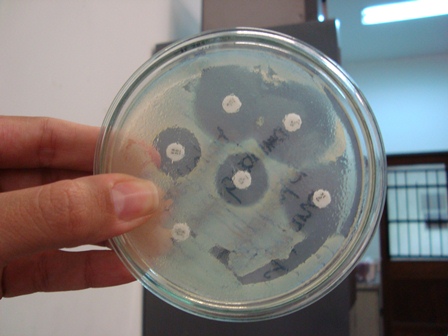
genetica.jpg

SEGUIR
SEGUIR
 SEGUINDO
|
Atualizado em 16 Maio - Publicado em 29 julho
SEGUINDO
|
Atualizado em 16 Maio - Publicado em 29 julho

 SEGUIR
SEGUIR
 SEGUINDO
|
Atualizado em 16 Maio - Publicado em 15 abril
SEGUINDO
|
Atualizado em 16 Maio - Publicado em 15 abril

OFERTA DIA DAS MÃES
Assine a revista OFERTA DIA DAS MÃES - A partir de R$ 9,90/mês





Essa é uma matéria exclusiva para assinantes. Se você já é assinante faça seu login
Este usuário não possui direito de acesso neste conteúdo. Para mudar de conta, faça seu login
